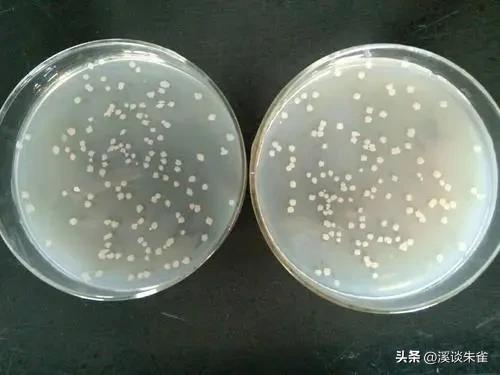
苏云金杆菌杀虫剂对蜜蜂有害吗,苏云金芽孢杆菌生物杀虫剂

文丨溪谈朱雀
编辑丨溪谈朱雀
在阅读之前,麻烦您点一下“关注”,方便您进行讨论和分享、增加阅读体验,感谢您的支持。
●—《前言》—●

苏云金芽孢杆菌(Bt)是一种昆虫致病菌,已被用作 全球害虫防治的生物杀虫剂 。这项工作的目的就是 评估Bt产品Dipel和Xentari的商业配方,对西方蜜蜂( Apis mellifera )的生存和行为可能会产生的影响。
经过对觅食者和出现的蜜蜂进行生物测定,这些蜜蜂接收了混合在食物中的产品。通过垂直位移测试和步行测试评估它们的生存和行为,并使用软件Bee-Move对其进行分析。
●—《苏云金芽孢杆菌的商业作用》—●

西方蜜蜂 L.(膜翅目:Apidae)物种分布广泛,觅食面广,可以成为环境污染的生物指标,它们也可用作监测器有助于 检测农用化学品,尤其是杀虫剂的存在对生态影响的表现 。
巴西需要授粉植物产生的经济贡献占年农业总收入的30%(12亿美元)(总计近45亿美元)。蜜蜂作为全球传粉剂,在这种情况下具有直接和间接的贡献。

然而,自2006年以来,有报道称菌落迅速减弱或丧失蜜蜂的作用,导致现在被定义为菌落崩溃障碍(CCD)的现象。与CCD相关的主要因素之一是广泛用于农作物的合成植物检疫产品,对蜜蜂产生了严重的污染,主要用于控制害虫。
在巴西,另一个新出现的问题是整个*麻疹荨**或部分*麻疹荨**的死亡率。通常,由于使用杀虫剂, 在蜂箱附近观察到数百只有中毒迹象的死蜜蜂 。

生物控制是化学控制的替代方案,将害虫的种群密度保持在可能造成经济损失的水平以下。这种控制方法被认为对非目标生物(如传粉媒介)更安全,在不同的生物控制剂中,苏云金芽孢杆菌(Bt)被认为 是成功高效的,推荐用于控制昆虫,包括鳞翅目、鞘翅目和膜翅目昆虫。
●—《生存生物测定》—●
当喂食含有Dipel或Xentari的Candi糊时,新出现的(24小时)蜜蜂的存活率没有差异。144 h后,对照处理(不处理的Candi Paste)、Dipel处理和Xentari处理的蜜蜂存活率分别为74%、80%和76%。

Kaplan-Meier的西方蜜蜂新出现的(24 h-h)工蜂的存活图,调整为用含有商业产品的Candi糊喂养后的时期(h)(T2,Dipel;T3,Xentari)或对照饮食(T1)。蜜蜂保持在受控环境中(26°C±2°C,RH,60%±10%;12小时光周期),相同的字母表明结果之间没有显著差异( p < 0.05)。
在觅食蜜蜂的生存生物测定中,也没有观察到用含有Dipel或Xentari的Candi糊喂养的蜜蜂或对照组的差异。

觅食蜂( A. mellifera )的生存图,由Kaplan-Meier绘制,调整为用含有商业产品的Candi糊喂养后的时期(h)(T2 , Dipel;T3,Xentari)或对照饮食(T1)。温度(26°C±2°C,相对湿度60%±10%;12小时光周期),相同的字母表明结果之间没有显着差异( p < 0.05)。
●—《垂直置换生物测定》—●
只有新出现的(24 小时大)工蜂喂食含有 Xentari 的 Candi 糊,垂直位移减少,无法达到塔内的最高水平。垂直置换生物测定中的觅食蜜蜂以及自由落体生物测定的觅食者和新出现的,在5%的显著性水平上没有表现出处理之间的统计学差异。

觅食者和新出现的(24 小时)工蜂 ( Apis mellifera ) 的垂直位移 ( A , B ) 和自由落体 ( C , D ),摄入结合指定处理的 Candi 糊状物 144 小时后,正方形表示每个处理的中位数值,具有相应的第一和第三四分位数。
蜜蜂的平均速度、覆盖距离、步行时间和休息时间不受产品中掺入的Candi糊的影响,进行该生物测定以评估蜜蜂摄入的产品对运动能力的可能影响。

西方蜜蜂在摄入与指定产品结合的Candi糊后24小时采取的路径。( A ) 新出现的工蜂A . mellifera (对照);( B ) A. mellifera 新出现的工蜂(Dipel);( C ) 新 出现的工蜂A.( D ) A. mellifera 觅食者工人(对照);( E ) A. mellifera 觅食工人(Dipel);( F ) A. mellifera 觅食者工人(Xentari)。
●—《组织学分析》—●
饲喂商业产品Dipel和Xentari的新出苗和觅食工人的平均绒毛长度在109.4μm至123.9μm之间,与对照处理没有显着差异。

苏云金双歧杆菌的致病性取决于 昆虫对细菌蛋白的摄入 ,Cry蛋白作为内毒素发挥作用,在与昆虫的中肠接触时被溶解,激活并在肠绒毛中起作用,导致离子失衡和毛孔的形成,从而导致消化道的破坏和昆虫的死亡。
在这项研究中,我们分析了Dipel和Xentari对新出现的(24小时)工蜂和觅食者西方蜜蜂( A. mellifera )发现没有负面影响。对照蜂表现出死亡率, 因为蜜蜂是群居昆虫,需要蜂王释放的信息素来控制活动。

由于生物测定中 没有蜂王,只有工蜂,这导致了相当大的死亡率 。此外,觅食蜂的年龄超过24小时工蜂,这就是为什么它们的死亡率更高。有几种苏 云金双歧杆菌 菌株能够产生不同的蛋白质,其毒性根据昆虫的目和种类而有所不同。
在我们的研究中,Xentari处理降低了垂直位移测定中24 h工蜂的飞行能力,他们达到了较低的飞行高度,并且难以到达塔顶的光源。有人强调,年轻的蜜蜂在接触产品时可能会受到更大的负面影响。

例如,已经观察到苯甲酸甲酯对蜜蜂飞行行为的更严重影响, 吡虫啉、吡丙氧芬、氯虫苯甲酰胺和氮杂拉丁,飞行行为的变化会影响花粉和花蜜的收集,影响殖民地的整个发育,以及周围作物的授粉。
尽管有这些结果,但发现产品Xentari和Dipel不会干扰西方蜜蜂(24小时龄和觅食者)的存活。在其他测试中,苏云金芽孢杆菌也被证明对梅利弗拉是安全的,不会导致死亡。并且,没有改变这些传粉者对大豆花的访问行为或运动活动,证实了我们的研究结果,该研究也没有发现暴露于细菌的昆虫的行为发生变化。

除此之外,观察到来自苏云金双歧杆菌的一些分离株不会对来自梅里芬拉的工蜂的成年和幼虫产生负面影响。不会引起亚致死效应,例如幼虫发育、食物消耗和成虫长鼻的延伸反应。
Dipel由苏云金双歧杆菌亚种 kurstaki 配制而成,含有蛋白质Cry1Aa,Cry1Ab,Cry1Ac,Cry2Aa和Cry1Ac,而Xentari由苏云金双歧杆菌变种 aizawai 配制而成,可产生Cry1Aa,Cry1B,Cry1Ca和Cry1Da,这可能是与观察到的24小时工蜂飞行能力差异有关的一个因素。

在本工作中,无法验证喂食不同产品或浓度的蜜蜂肠系膜绒毛长度之间的差异。当西方成年蜜蜂喂食含有苏云金双歧杆菌HD-1的饮食时,观察到类似的结果,以及在喂食含有苏云金芽孢杆菌蛋白(Cry1C 或 Cry2A)的饮食的幼虫的研究中也出现了这样的情况。
然而,德乌尔索等人发现苏云金双歧杆菌治疗后96h发生肠道变化。尽管明显没有毒性(即蜜蜂的存活率没有改变),但摄入Bt的蜜蜂的肠上皮可能会长期发生一些急性影响。这可能会掩盖对蜜蜂有害的其他生理干扰,特别是在暴露于生物制品与其他环境压力因素相结合的情况下。

用Bt玉米花粉喂养的哺乳蜜蜂的肠道细菌表达三种杀虫Cry蛋白(Cry1A.105,Cry2Ab2和Cry3Bb1),没有显示出差异,就像Cry1Ie毒素在实验室条件下没有改变工蜂意大利蜜蜂和中华蜜蜂的中肠细菌一样。
商业产品Dipel和Xentari都含有苏云金双歧杆菌,当掺入蜜蜂Candi糊中时,不会影响新出现的和觅食的梅里弗拉工蜂的存活。Xentari产品降低了蜜蜂恢复飞行的能力,无论是新出现的还是觅食者工人。
然而,这些产品不影响西方蜜蜂的其他行为活动,并且被证明对这些昆虫是安全的。与在实验室中一样,蜜蜂被迫接触含有Bt的产品,而喂食基于Bt的产品的蜜蜂在存活和评估行为方面没有显著差异,没有必要将这个实验带到接触条件较少的现场。
虽然两种产品都表现出对 梅氏蕨 的选择性和安全性,但建议应注意施用过程,避免与工蜂的觅食期相吻合。这对于避免觅食者通过运输在菌落内可能造成的污染以及避免对其飞行行为产生负面影响非常重要。

●—《获取昆虫和产品》—●
西方蜜蜂新出现时:将具有19天龄工蜂(蛹期)的框架从蜜蜂繁殖实验室(UNEPE-Apicultura)中取出并带到生物控制实验室,在那里将它们转移到穿孔牛皮纸袋中并保存在气候控制室(34°C±2°C)中, 相对湿度为60%±5%),持续2-3天,直到成年工蜂出现。
觅食者意大利蜜蜂:在每个蜂群的入口处,使用聚氯乙烯(PVC)笼子(高20厘米×直径10厘米)来捕获从田间返回的蜜蜂。使用了来自10个蜂群的蜜蜂,并随机选择蜜蜂,以免干扰所使用的蜂群。这两组蜜蜂被用来验证苏云金芽孢杆菌对这种昆虫不同年龄的生存和行为的影响。

新出现的(24 小时)工蜂和觅食者蜜蜂通过暴露于一氧化碳麻醉至60秒,实验单元由一个PVC笼(高20厘米×直径10厘米)组成,里面装有20只蜜蜂,并用巴里纱织物封闭。
此外,由纯Candi糊(对照)或Candi糊组成的饮食与结合的治疗(Dipel和Xentari)(方法改编自Carvalho等人)。每天用水将棉花浸的润湿。将笼子保存在气候控制的房间(26°C±2°C,RH,60%±10%,12小时光周期)。每次治疗包括5次重复,20只蜜蜂,每次治疗总共100只蜜蜂。

在将产品掺入饲料后1,2,3,4,5,6,9,12,15,18,21,24,30,36,42,48,60,72,96,120和144小时进行蜜蜂死亡率的评估(方法改编自Baptista等人)。
144h后,随机选择10只接受每种处理的蜜蜂进行垂直位移和自由落体评估。评估在一个黑暗的房间里进行,使用垂直塔(35厘米×35厘米宽,105厘米高),顶部有光源,塔内有五层。

对于垂直位移测试,将蜜蜂放置在塔的底部1分钟,并记录行为和达到的最大高度(方法改编自Tomé等人。与此相辅相成的是,使用同一塔进行自由落体测试,蜜蜂在塔顶被释放,并记录蜜蜂恢复飞行的水平。
使用生物目生物光学显微镜分析包含切片的载玻片,该显微镜包含一个用于图像捕获和绒毛长度测量的镜头。发现Bt蛋白可以改变以它为食的昆虫肠系膜的绒毛和微绒毛,因此测量肠绒毛以检查细菌蛋白引起的可能组织学变化非常重要。

●—<参考文献>—●
【1】Celli,G.&Maccagnani(2003)《养蜜蜂作为环境污染的生物指标》
【2】Hung, K.-L.J.(2018)《蜜蜂作为自然栖息地传粉媒介的全球重要性》
【3】Giannini, T. C.(2015)《巴西作物对授粉媒介的依赖和授粉的经济价值》
【4】加里波第(2016)《洛杉矶等小型和大型农场的互利传粉媒介多样性和作物产量结果》
【5】Calderone,N.W.(2012)《昆虫授粉作物,昆虫授粉媒介和美国农业》
【6】卡普兰,J.K.(2012)《殖民地崩溃障碍:一个不完整的谜题》